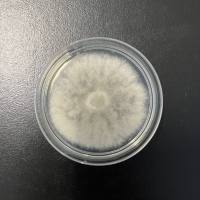
厄氏菌属

- 详细信息
- 技术资料
- 库存:
1000
- 英文名:
Arthrobacter ramosus
- 保质期:
15年
- 供应商:
北京百欧博伟生物技术有限公司
- 保存条件:
2-8度
收藏时间:2007/11/5
原始编号:321-40
原产国:中国
模式菌株:非模式菌株
主要用途:分类;研究;教学
特征特性:细菌菌体呈杆状,多聚排列,菌落直径约2-3mm,菌落为圆形,粉红色,不透明,表面光滑,边缘整齐。细菌无荚膜,无芽孢,革兰氏染色为阳性。细菌通过裂殖进行繁殖。该细菌为异养型细菌,在生长过程中需要氧气,不需要光照,过氧化氢酶反应显示为阴性,氧化酶反应为阴性。该细菌的最适生长温度为30 oC左右,最适环境pH为7.0左右。该细菌在生长过程中不需要添加生长因子和其他营养物质。碳源代谢分析显示其生长过程中利用的碳源,氮源和其他有机类物质主要有吐温80,糊精,熊果苷等。
具体用途:
生物危害程度:四类
寄主名称:
致病对象:无
致病名称:
传播途径:
分离基物:土壤
采集地:新疆
培养基编号:820
培养温度:30℃
原始编号:321-40
原产国:中国
模式菌株:非模式菌株
主要用途:分类;研究;教学
特征特性:细菌菌体呈杆状,多聚排列,菌落直径约2-3mm,菌落为圆形,粉红色,不透明,表面光滑,边缘整齐。细菌无荚膜,无芽孢,革兰氏染色为阳性。细菌通过裂殖进行繁殖。该细菌为异养型细菌,在生长过程中需要氧气,不需要光照,过氧化氢酶反应显示为阴性,氧化酶反应为阴性。该细菌的最适生长温度为30 oC左右,最适环境pH为7.0左右。该细菌在生长过程中不需要添加生长因子和其他营养物质。碳源代谢分析显示其生长过程中利用的碳源,氮源和其他有机类物质主要有吐温80,糊精,熊果苷等。
具体用途:
生物危害程度:四类
寄主名称:
致病对象:无
致病名称:
传播途径:
分离基物:土壤
采集地:新疆
培养基编号:820
培养温度:30℃
风险提示:丁香通仅作为第三方平台,为商家信息发布提供平台空间。用户咨询产品时请注意保护个人信息及财产安全,合理判断,谨慎选购商品,商家和用户对交易行为负责。对于医疗器械类产品,请先查证核实企业经营资质和医疗器械产品注册证情况。
技术资料暂无技术资料 索取技术资料
分枝节杆菌
询价